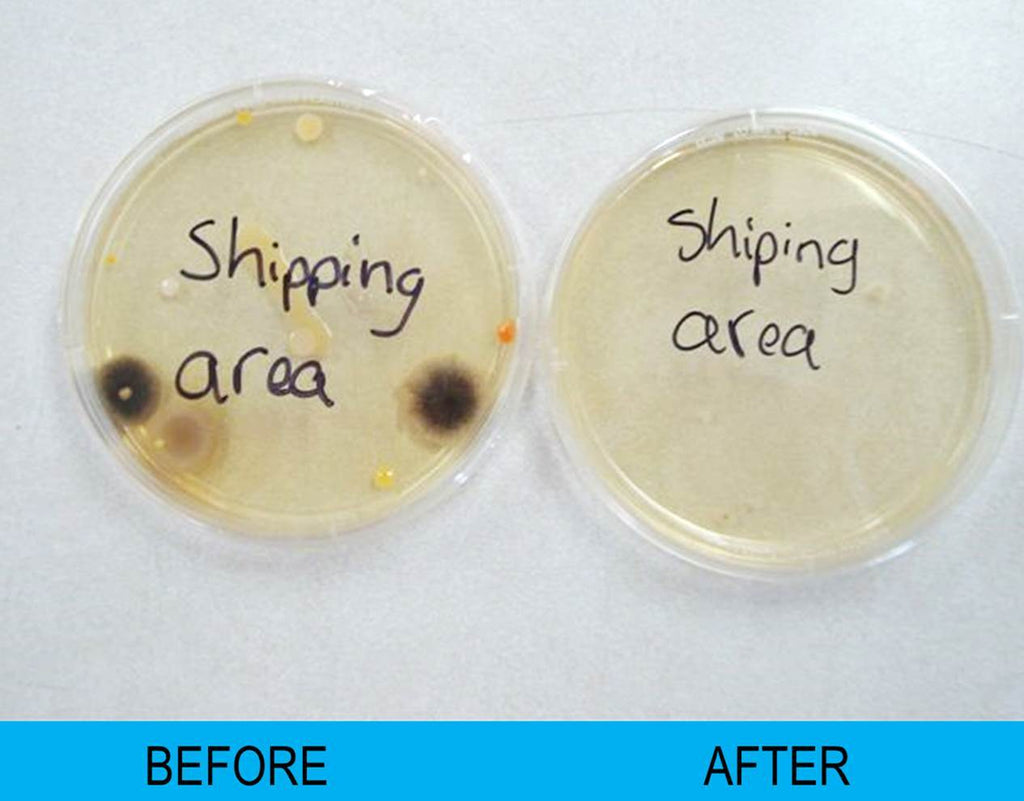
Air Quality Test Kit
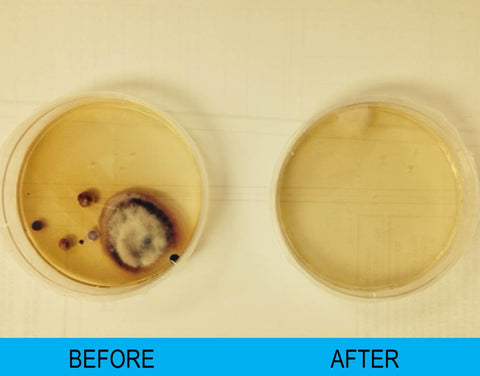
Image of Air Quality Test Kit
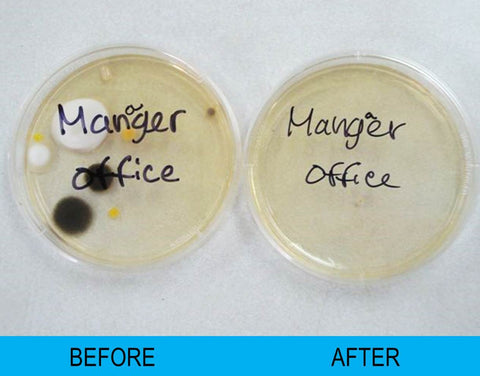
Image of Air Quality Test Kit

Air Quality Test Kit
Viewing This Product
NOTE: Actual price may vary on their website.
BONUS! Get a free 30 day trial to the Extreme Health Academy by buying through our store. Email justin@extremehealthradio.com with your receipt!
Includes Two Petri Dishes for Testing. Test your home or office for: mold, bacteria, yeast, and more! Air quality testing has various degrees of exactness and expense. We sell a DIY petri dish kit that we purchase in bulk from a lab which allows our customers to conduct visual testing of biological contaminants like mold, bacteria and viruses. It does not test for other pollutants like odors, chemical gases (VOCs), and physical particulates.
See the results yourself, but feel free to send us a picture of your test for additional analysis and advice.
Includes Two Petri Dishes for Testing. Test your home or office for: mold, bacteria, yeast, and more! Air quality testing has various degrees of exactness and expense. We sell a DIY petri dish kit that we purchase in bulk from a lab which allows our customers to conduct visual testing of biological contaminants like mold, bacteria and viruses. It does not test for other pollutants like odors, chemical gases (VOCs), and physical particulates.
See the results yourself, but feel free to send us a picture of your test for additional analysis and advice.